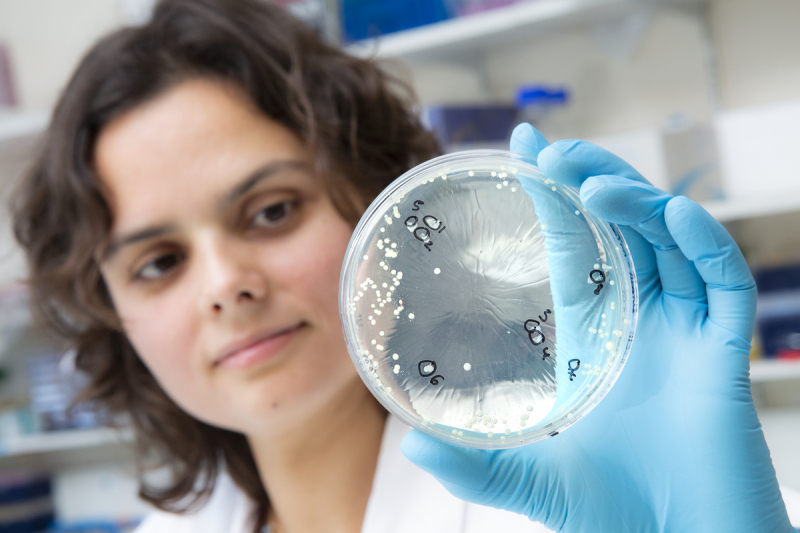
Une biologiste étudie les parasites responsables du paludisme à l'aide de bactéries

Plan d’action pour l’égalité professionnelle 2024-2026 du CNRS : « Transformer une dynamique collective en actions concrètes »
À l’occasion de la Journée internationale des femmes et des filles de science le 11 février, le CNRS publie son nouveau plan d’action pour l’égalité professionnelle. Bien plus qu’une réponse à une obligation légale, c’est l’occasion pour chacune et chacun, de la gouvernance jusque dans les laboratoires, de s’approprier les politiques d’égalité et de devenir acteur du changement.
L’égalité professionnelle entre les femmes et les hommes constitue un engagement fort du CNRS depuis plus de 20 ans. Premier établissement de l’enseignement supérieur et de la recherche à créer une structure dédiée, la Mission pour la place des femmes (MPDF), le CNRS en a fait une priorité. « Garantir les mêmes conditions de recrutement, de progression de carrière et de rémunération aux femmes et aux hommes est un enjeu essentiel pour notre société et pour le CNRS », comme le rappelle avec force et conviction le PDG. « Depuis plusieurs années, une véritable dynamique a été impulsée », constate Elisabeth Kohler, directrice de la MPDF. Ce qui a changé au CNRS, c’est qu’on parle de plus en plus d’égalité entre les femmes et les hommes, que de plus en plus d’acteurs s’engagent pour mettre en œuvre des actions concrètes. Tous les instituts sont représentés au sein du comité parité-égalité du CNRS et certains d’entre eux ont déjà mis en place des actions très structurantes au niveau de leurs communautés scientifiques. Les délégations régionales ont désigné des correspondantes et correspondants égalité dans chacune des circonscriptions et organisent de nombreuses actions au niveau régional et local. De plus en plus de laboratoires s’emparent du sujet et disposent désormais de référentes et référents égalité (près de 500 au total), fonctionnant en réseaux coordonnés soit par les délégations régionales soit par les instituts. « L’objectif est de transformer une dynamique collective en actions concrètes dans l’ensemble des unités et structures du CNRS », précise Elisabeth Kohler.
Analyser, comprendre, agir : les fondements du plan
Loin de constituer une simple réponse à une obligation légale instaurée par la Loi de transformation de la fonction publique1 , ce plan d’action a pour objectif de remédier concrètement aux inégalités professionnelles entre les femmes et les hommes. Afin de définir les actions les plus pertinentes, la MPDF se fonde sur l’analyse des chiffres issus du Rapport social unique, les résultats provenant de différentes études et enquêtes approfondies menées au niveau du CNRS, comme concernant les écarts de rémunération, ainsi que sur une abondante littérature scientifique internationale permettant de mieux comprendre les mécanismes conduisant aux inégalités, tels que les biais de genre, l’impact de la parentalité, le sexisme.
Co-construit avec différents acteurs (DRH, comité parité-égalité, représentantes et représentants des délégations régionales et laboratoires) et validé par la direction du CNRS et les organisations syndicales, ce nouveau plan d’action fait suite à celui de 2021-2023 en prolongeant et renforçant certaines actions tout en ouvrant de nouveau domaines.
- 1La loi du 6 août 2019 de transformation de la fonction publique est une vaste réforme. Ses objectifs s’inscrivent dans le programme « Action publique 2022 », qui vise à accélérer la transformation du service public. Elle prévoit notamment de renforcer l'exemplarité des administrations en matière de déontologie et d'égalité professionnelle.
Attirer, recruter, promouvoir : remédier aux biais de genre
Comme l’atteste la raréfaction du vivier de candidates dans des disciplines comme les mathématiques, la physique, le numérique ou les sciences de l’ingénieur, attirer les femmes vers des métiers scientifiques n’est pas chose simple. Pour cause, des études ont démontré que les enfants intègrent l’idée d’une infériorité des femmes par rapport aux hommes dans les disciplines scientifiques et techniques dès l’âge de six ans. « Il faut faire prendre conscience de ces stéréotypes sociaux qui perdurent et induisent des inégalités tout au long des carrières et mettre en place des actions pour remédier à leurs effets », explique Elisabeth Kohler.
Comme précédemment, le CNRS continuera à mener des actions de communication pour renforcer l’attractivité des métiers scientifiques auprès des jeunes femmes, notamment à travers des rôles modèles féminins. Vis-à-vis des doctorantes et post-doctorantes, de nouvelles actions de mentorat vont être menées afin de mieux accompagner ces jeunes femmes dans leur carrière.
Au niveau des recrutements et promotions de chercheuses, bon nombre d’actions du précédent plan vont être reconduites et renforcées au vue de leurs résultats positifs. En effet, grâce à ces actions la proportion de femmes dans les recrutements de personnel chercheur a ainsi été bien supérieure dans la période 2020-2022 (39,4 % de femmes parmi les recrues) que durant la période précédente (36,3 % entre 2017 et 2019). Toutefois seule une petite partie des effectifs étant renouvelés chaque année, l’impact de ces recrutements sur la féminisation des effectifs reste nécessairement faible (34,3 % de femmes parmi le personnel chercheur en 2019 et 34,7 % en 2022). D’autre part, on constate une réduction du plafond de verre : la proportion de femmes DR est passé de 30,1 % en 2019 à 31,7 % en 2022. Dans le même temps, le pourcentage de directrices d’unité est passé de 22,4 % à 25 %.
Les actions suivantes vont donc être maintenues ou renforcées pour la période 2024-2026 :
- Continuer à sensibiliser les membres des sections et CID du comité national aux biais de genre
- Maintenir la présence de référentes et référents parité dans les sections et CID du comité national
- Continuer à appliquer le principe des promotions en « cascade » (proportion de femmes promues égale ou supérieure à la proportion parmi les promouvables)
- Renforcer l’accompagnement des carrières pour l’accès aux postes à responsabilité
- Augmenter le nombre de directrices d’unités.
À la différence du précédent plan, où ces mesures visaient essentiellement la carrière des chercheuses, le plan d’action 2024-2026 entend étendre celles-ci aux personnels ingénieurs et techniciens (IT). « Il faut casser le plafond de verre actuel. En effet, si la parité est atteinte globalement chez les IT, plus on monte dans la hiérarchie des corps moins les femmes sont présentes (32 % chez les ingénieurs de recherche contre 66 % chez les techniciens). Nous devons également tout faire pour augmenter la mixité dans ces métiers alors qu’il n’y a que 12 % de femmes en BAP C (sciences de l’ingénieur et instrumentation scientifique) contre 84 % en BAP J (gestion et pilotage) », rappelle Elisabeth Kohler.
De nouvelles actions ont donc été inscrites dans le plan d’action 2024-2026 :
- Sensibiliser les jurys de concours et de promotion IT aux biais de genre
- Promouvoir une rédaction non stéréotypée des fiches de postes
- Renforcer l’attractivité des métiers très masculins pour les femmes et inversement
- Sensibiliser les encadrants en charge des évaluations annuelles aux biais de genre.
L’ensemble de ces actions contribuera aussi à réduire les écarts de rémunération, dont les mécanismes ont été analysés en profondeur dans le cadre du plan d’action pour l’égalité 2021-2023.
Réduire l’impact de la parentalité sur les carrières
Le soutien à la parentalité, dont l’essentiel de la charge continue à être assumée par les femmes comme le montrent toutes les études, constitue autre un enjeu majeur. Le congé maternité et la parentalité impactent ainsi lourdement la carrière des femmes jusque dans le nombre de leurs publications, leur participation aux appels à projets et manifestations scientifiques. Certaines mesures ont déjà été initiées lors du précédent plan et seront prolongées, tels qu’un soutien financier aux unités pour permettre une prolongation d’un contrat en CDD d’une durée équivalente au congé maternité ; la préconisation de chartes du temps ou d’entretiens pré- et post congé maternité ou parental ; l’adoption de critères pour réduire l’impact d’un congé maternité dans l’évaluation des dossiers par les sections du Comité national ; l’incitation pour les pères à prendre à prendre le congé d’accueil de l’enfant et participer à des entretiens d’accompagnement à la parentalité.
En outre, de nouvelles actions sont prévues dans le plan d’action 2024-2026 :
- Maintenir les primes du complément indemnitaire annuel à leur taux plein pour les femmes prenant un congé maternité
- Veiller à ce que la proportion d’agents ayant eu un congé maternité ou prenant un temps partiel lié à la parentalité soient promus dans une proportion égale ou supérieure à celle des promouvables.
Dans les limites de la règlementation, des mesures de prise en charge de frais de garde d’enfants (crèches éphémères…) pourront également être mises en œuvre.
Prévenir et lutter contre les violences sexistes et sexuelles
Plusieurs études tant au niveau du CNRS qu’au niveau national ou international montrent la persistance de violences sexistes ou sexuelles dans l’enseignement supérieur et la recherche. Dès 2021-2023, le CNRS a mis en place des mesures fortes avec la création d’une cellule de signalement et d’une cellule d’écoute pour les victimes et témoins directs. De nombreuses sessions de sensibilisation et de formation ont été organisées à destination des directrices et directeurs d’unité, ainsi que des référentes et référents en laboratoires. Dans une volonté d’approfondissement de sa politique de prévention et de lutte contre les violences sexistes et sexuelles, le CNRS poursuivra et renforcera en 2024-2026 ses actions de sensibilisation et de formation à destination des personnels encadrants ainsi que de tous les agents.
Les politiques d’égalité : un enjeu global
Enfin, le plan d’action 2024-2026 va plus loin que le précédent en proposant d’intégrer l’égalité dans l’ensemble des politiques du CNRS, comme la coopération internationale. Il souhaite également mieux valoriser les recherches sur les questions d’égalité et d’intégration de la dimension du genre, non seulement dans le domaine des sciences humaines et sociales mais également dans le domaine des sciences biologiques et de la santé ou encore de l’intelligence artificielle. Elisabeth Kohler conclut : « En tant qu’organisme de recherche, le CNRS doit montrer l’importance d’établir des politiques d’égalité fondées sur des résultats scientifiques et qui répondent aux défis sociétaux ».